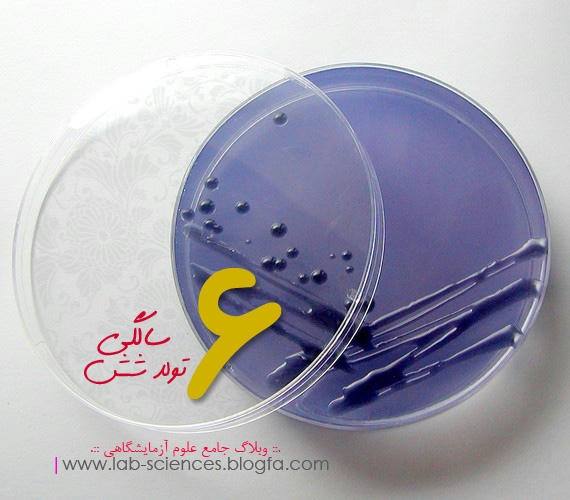
تولد شش سالگی وبلاگ جامع علوم ازمایشگاهی

حتما برای شما جالب خواهد بود زمانی که یک ربات وظیفه خونگیری و پیدا کردن رگ را انجام دهد. قبلا در مورد عینک رگ یاب و همچنین وسائل رگ یاب دیگر بحث کرده بودیم ولی این دفعه پا را فراتر گذاشته و محصولی از شرکت Start-Up برای شما معرفی می کنیم در زمینه خون گیری همه کاره هست.این ربات بر روی انسان ازمایش شده است و می تواند رگ را پیدا کند و خون گیری انجام دهد. سیستم هسته ای ویژه ای که (تحت عنوان Veebot) در این ربات قرار داده شده است این قابلیت را به این ربات می دهد. برای انجام خودکار یافتن رگ دانشمندان بیولوژیست روشی را اختراع کرده اند که در این روش رگ های بازو به صورت برخط و دائم مانیتور و بررسی می شود و در 83% موارد رگ مناسب را برای خون گیری به درستی انتخاب می کند. مختراعان بر تلاش هستند تا قبل از مرحله تجاری میزان دقت آن را به بالای 90% برساند. این ربات می تواند هزینه های جاری ازمایشگاه یا بیمارستان را کاهش دهد و همچنین میزان خطر یا نیدل استیک شدن بچه های ازمایشگاهی را از بین ببرد. دستگاه خودکار خونگیری از روش های فراصوت، مادون قرمز و همچنین نمای کامپیوتری رگ مناسب را پیدا میکند. مادون قرمز و آنالیز کامپیوتری برای یافتن رگ و فراصوت برای خون گیری است. تورنیکت این دستگاه هم مثل خودش خودکار است. کل مدت زمات خون گیری توسط این دستگاه در کل یک دقیقه خواهد بود. برای کسب اطلاعات بیشتر در این زمینه به سایت این شرکت (اینجا) مراجعه کنید.


برچسبها: automated venipuncture system, Veebot, خون گیری خودکار, دستگاه خون گیر